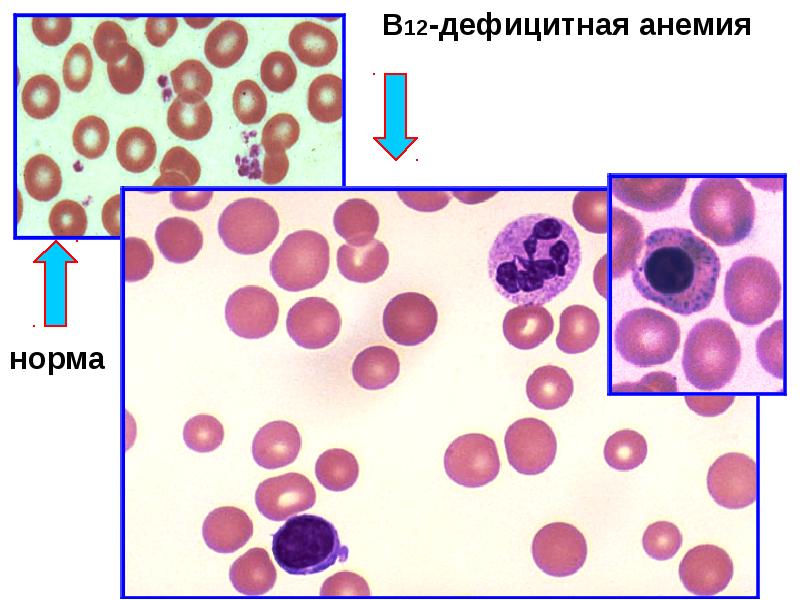

Фуникулярный миелоз анемия
Чтение строки питон
Для чего используют мастику
Цю эр боевой континент
5 уги
Всеобщая история 7 класс параграф 10 слушать
25 3 6 в столбик
Адреса улиц в питере
Морская нереида обитает в бескислородной среде
Как назвать ваську
Определить окрас котят
Куфар коробки
Сказочный мальчик путешествующий на диких гусях кроссворд
Ростове на дону садовая 128
Фуникулярный миелоз анемия 115 фото